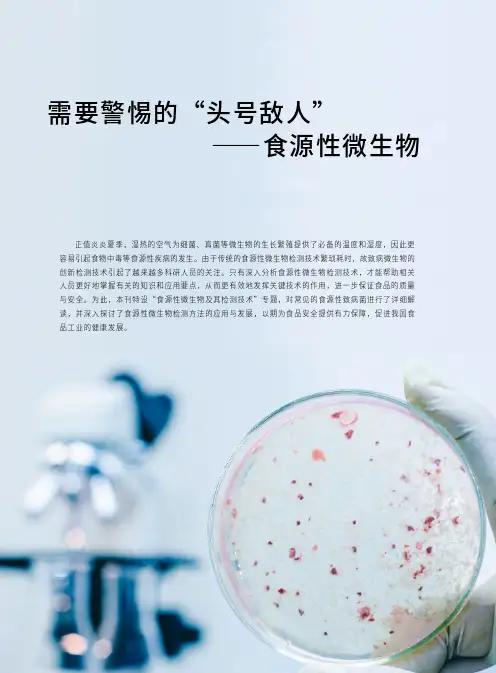

食品微生物之检验方法-阪崎肠杆菌之检验
- 格式:doc
- 大小:170.50 KB
- 文档页数:15

长春阪崎肠杆菌科鉴定流程肠杆菌科是一类重要的革兰氏阴性菌,包括了大肠杆菌、沙门氏菌、鲍曼不动杆菌等多种细菌。
其中,长春阪崎肠杆菌是一种致病菌,能够引起食物中毒、泌尿生殖道感染等疾病,因此对其的鉴定非常重要。
下面介绍一下长春阪崎肠杆菌科鉴定的流程。
1. 样本采集首先,需要对患者的样本进行采集。
常见的样本包括粪便、血液、尿液等。
在采集样本的过程中,需要注意保持样本的无菌状态,避免外界细菌的污染。
2. 细菌培养然后,需要将样本进行细菌培养。
将样本接种到适宜的寒暖贮藏培养基上,进行培养。
需要注意控制培养基的温度、湿度等条件,保证细菌能够生长繁殖。
3. 形态观察在细菌培养的过程中,需要不断观察菌落的形态、颜色等特征。
长春阪崎肠杆菌的菌落一般为圆形或不规则形状的,表面光滑或稍微粗糙。
颜色一般为乳白色、淡黄色或灰白色。
4. 生化试验接下来,需要进行生化试验。
长春阪崎肠杆菌一般可以通过氧化-发酵反应、氧化酶试验、甲烷蓝试验等生化试验进行鉴定。
其中,氧化-发酵反应是一种常见的鉴定方法,可根据菌落的形态、气泡、酸碱度等鉴定细菌。
氧化酶试验可检测细菌是否含有氧化酶,通过观察菌液的颜色、气味等来判断。
甲烷蓝试验可检测细菌是否能够分解葡萄糖产生酸。
5. 分子生物学检测最后,对于一些难以通过传统生化试验鉴定的长春阪崎肠杆菌,可以进行分子生物学检测。
常见的分子生物学检测方法包括PCR、DNA测序等,能够检测菌株的基因序列,进一步确认菌株的种属。
总之,长春阪崎肠杆菌科的鉴定流程是一个较为复杂而严格的过程,需要仔细控制每一个步骤,细致地观察每一项指标,保证鉴定结果的准确性。

检测认证乳粉中克罗诺杆菌属(阪崎肠杆菌)能力验证PCR技术的探索■ 仇平平 田 梦 孙巧巧(济宁市食品药品检验检测研究院)摘 要:为提高实验室检测克罗诺杆菌属(阪崎肠杆菌)的能力,本文依据NIFDC-PT-384乳粉中克罗诺杆菌属(阪崎肠杆菌)检验能力验证作业指导书、GB 4789.40-2016《食品安全国家标准 食品微生物学检验 克罗诺杆菌属(阪崎肠杆菌)检验 》,探索传统生化方法和PCR技术相结合的检测克罗诺杆菌属(阪崎肠杆菌)的方法。
结果表明,样品CODE12未检出克罗诺杆菌属(阪崎肠杆菌),样品CODE19检出克罗诺杆菌属(阪崎肠杆菌),结果均为满意。
本实验室具备检验克罗诺杆菌属(阪崎肠杆菌)的能力,PCR技术很好地印证了传统生化实验的结果。
关键词:乳粉,克罗诺杆菌属(阪崎肠杆菌),能力验证,PCR技术DOI编码:10.3969/j.issn.1002-5944.2023.16.028Exploration of PCR Technique for the Ability Verifi cation of Cronobacter Spp. (Enterobacter Sakazakii) in Milk PowderQIU Ping-ping TIAN Meng SUN Qiao-qiao(Jining Institute for Food and Drug Control)Abstract:To improve the ability of laboratory detection of Cronobacter Sakazakii (Enterobacter Sakazakii), this paper explores a method for the detection of Cronobacter Sakazakii (Enterobacter Sakazakii) by combining traditional biochemical methods with PCR. According to the operation instruction for verification of Cronobacter spp. (Enterobacter Sakazakii) testing ability in milk powder of NIFDC-PT-384 and GB 4789.40-2016 for food safety microbiology test. The results show that Cronobacter spp. (Enterobacter Sakazaki i) was not detected in sample CODE12, and Cronobacter (Enterobacteriaceae) was detected in sample CODE19, the results were satisfactory. Our laboratory has the ability to test Cronobacter spp. (Enterobacter Sakazakii), and PCR has well confi rmed the results of traditional biochemical experiments.Keywords: milk powder, Cronobacter spp. (Enterobacter sakazakii), profi ciency testing, PCR techniquen0 引 言克罗诺杆菌属(Cronobacter spp.)是肠杆菌科内一类短杆状革兰氏阴性菌,1980年以前被称为“产黄色素阴沟肠杆菌(yellow-pigmented Enterobacter cloacae)”,1980 年更名为阪崎肠杆菌(Enterobacter sakazakii),2008年被重新定义为一个新属,即克罗诺杆菌属[1-2]。




食品微生物之检验方法-阪崎肠杆菌之检验1 适用范围:本方法适用于一般食品及奶粉中阪崎肠杆菌之检验。
2 检验方法:2.1 工作环境:工作平台须宽敞、洁净、光线良好,操作平台光度为100呎烛光以上,密闭室内换气良好,尽可能没有灰尘及流动空气。
每15分钟落菌数不得超过15 CFU/培养皿。
2.2 器具及材料:2.2.1 干热灭菌器。
2.2.2 高压灭菌釜。
2.2.3 搅拌均质器(Blender)或铁胃(Stomacher):适用于无菌操作者。
2.2.4 天平:可称量到2000 g者,灵敏度为0.1 g;可称量到120 g者,灵敏度为1 mg。
2.2.5 冰箱:能维持5 ± 3℃者。
2.2.6 吸管或吸管尖:已灭菌,1 mL吸管应有0.01 mL之刻度;5 mL及10 mL吸管应有0.1 mL 之刻度。
2.2.7 吸管辅助器(Pipette aid)或微量分注器。
2.2.8 稀释瓶:160 mL,玻璃、聚乙烯(polyethylene)、铁弗龙(Teflon)或其它能耐121℃湿热灭菌20分钟以上之塑料材质,附螺旋盖。
2.2.9 培养皿:已灭菌,内径约9 cm,深度约15 mm,底皿之内外面应平坦,无气泡、刮伤或其它缺点。
2.2.10 增菌用容器:附螺旋盖之125 mL、250 mL、2 L三角锥瓶或广口瓶;玻璃、聚乙烯、铁弗龙或其它能耐121℃湿热灭菌20分钟以上之塑料材质。
2.2.11 pH测定仪。
2.2.12 培养箱:能维持内部温度在± 1℃以内者。
2.2.13 温度计:量测温度范围1~55℃,最小刻度0.1℃。
2.2.14 水浴:加盖,具水流循环系统,能维持水温温差在± 0.2℃以内者。
2.2.15 接种针及接种环(直径约3 mm):镍铬合金、铂铱或铬线材质,或可抛弃式者。
2.2.16 曲玻棒:可灭菌者,直径3~4 mm,涂抹区域45~55 mm。
2.2.17 试管:10 × 100 mm,13 × 100 mm,13 × 120 mm,15 × 150 mm,16 × 150 mm试管,或其它适用者。


食品微生物之检验方法-阪崎肠杆菌之检验1 适用范围:本方法适用于一般食品及奶粉中阪崎肠杆菌之检验。
2 检验方法:2.1 工作环境:工作平台须宽敞、洁净、光线良好,操作平台光度为100呎烛光以上,密闭室内换气良好,尽可能没有灰尘及流动空气。
每15分钟落菌数不得超过15 CFU/培养皿。
2.2 器具及材料:2.2.1 干热灭菌器。
2.2.2 高压灭菌釜。
2.2.3 搅拌均质器(Blender)或铁胃(Stomacher):适用于无菌操作者。
2.2.4 天平:可称量到2000 g者,灵敏度为0.1 g;可称量到120 g者,灵敏度为1 mg。
2.2.5 冰箱:能维持5 ± 3℃者。
2.2.6 吸管或吸管尖:已灭菌,1 mL吸管应有0.01 mL之刻度;5 mL及10 mL吸管应有0.1 mL 之刻度。
2.2.7 吸管辅助器(Pipette aid)或微量分注器。
2.2.8 稀释瓶:160 mL,玻璃、聚乙烯(polyethylene)、铁弗龙(Teflon)或其它能耐121℃湿热灭菌20分钟以上之塑料材质,附螺旋盖。
2.2.9 培养皿:已灭菌,内径约9 cm,深度约15 mm,底皿之内外面应平坦,无气泡、刮伤或其它缺点。
2.2.10 增菌用容器:附螺旋盖之125 mL、250 mL、2 L三角锥瓶或广口瓶;玻璃、聚乙烯、铁弗龙或其它能耐121℃湿热灭菌20分钟以上之塑料材质。
2.2.11 pH测定仪。
2.2.12 培养箱:能维持内部温度在± 1℃以内者。
2.2.13 温度计:量测温度范围1~55℃,最小刻度0.1℃。
2.2.14 水浴:加盖,具水流循环系统,能维持水温温差在± 0.2℃以内者。
2.2.15 接种针及接种环(直径约3 mm):镍铬合金、铂铱或铬线材质,或可抛弃式者。
2.2.16 曲玻棒:可灭菌者,直径3~4 mm,涂抹区域45~55 mm。
2.2.17 试管:10 × 100 mm,13 × 100 mm,13 × 120 mm,15 × 150 mm,16 × 150 mm试管,或其它适用者。

备案号:ICS SN中华人民共和国国家质量监督检验检疫总局发布前 言SN/T XXXX-XXXX《食品中多种致病菌快速检测-PCR方法》分为十一个部分:─ 第 1 部分:食品中沙门氏菌检测方法;─ 第 2 部分:食品中志贺氏菌检测方法;─ 第 3 部分:食品中金黄色葡萄球菌检测方法;─ 第 4 部分:食品中小肠结肠炎耶尔森氏菌检测方法;─ 第 5 部分:食品中单核细胞增生李斯特氏菌检测方法;─ 第 6 部分:食品中空肠弯曲菌检测方法;─ 第 7 部分:食品中肠出血性大肠埃希氏菌 O157:H7检测方法;─ 第 8 部分:食品中副溶血性弧菌检测方法;─ 第 9 部分:食品中霍乱弧菌检测方法;─ 第 10 部分:食品中创伤弧菌检测方法;─ 第 11 部分:食品中阪崎肠杆菌BAX®全自动PCR检测方法。
本标准修改采用Government of Canada Laboratory Procedure MFLP-27 THE DUPONT QUALICON BAX®1) SYSTEM METHOD FOR THE DETECTION OF ENTEROBACTER SAKAZAKII IN SELECTED FOODS (2003.9)本标准的附录A是资料性附录。
本标准由国家认可监督管理委员会提出并归口。
本标准起草单位:中华人民共和国辽宁出入境检验检疫局。
本标准起草人:卢行安等。
本标准系首次发布的检验检疫行业标准。
1) 为美国杜邦公司(DuPont Qualicon)产品。
食品中多种致病菌快速检测-PCR方法第11部分:食品中阪崎肠杆菌BAX®全自动PCR检测方法1 范围本部分规定了用BAX®全自动PCR技术快速检测阪崎肠杆菌的方法。
本部分适用于食品中阪崎肠杆菌的检验。
2 规范性引用文件下列文件中的条款通过本标准的引用而成为本标准的条款。
凡是注日期的引用文件,其随后所有的修改单(不包括勘误的内容)或修订版均不适用于本标准,然而,鼓励根据本标准达成协议的各方研究是否可使用这些文件的最新版本。
正值炎炎夏季,湿热的空气为细菌、真菌等微生物的生长繁殖提供了必备的温度和湿度,因此更容易引起食物中毒等食源性疾病的发生。
由于传统的食源性微生物检测技术繁琐耗时,故致病微生物的创新检测技术引起了越来越多科研人员的关注。
只有深入分析食源性微生物检测技术,才能帮助相关人员更好地掌握有关的知识和应用要点,从而更有效地发挥关键技术的作用,进一步保证食品的质量与安全。
为此,本刊特设“食源性微生物及其检测技术”专题,对常见的食源性致病菌进行了详细解读,并深入探讨了食源性微生物检测方法的应用与发展,以期为食品安全提供有力保障,促进我国食品工业的健康发展。
需要警惕的“头号敌人”——食源性微生物食源性微生物及其检测技术Aug 2019 CHINA FOOD SAFETY21食品安全问题一直是社会各界关注的重点。
世界卫生组织曾报道称,食源性疾病是受全球关注的卫生问题,更是影响人类健康的重要因素,而病原微生物感染则是导致食源性疾病发生的主要因素。
阪崎肠杆菌在2002年被国际食品微生物标准化委员会(ICMSF)确定为食源性致病菌,如被阪崎肠杆菌感染可能会引起婴幼儿尤其是新生儿患病,如脑膜炎、菌血症及坏死性小肠结肠炎等,更有甚者会引起严重的后遗症或死亡。
有数据显示,目前只有婴幼儿奶粉与这一疾病的爆发相关。
传统的致病微生物检测方法有国标法和纸片法,但因操作复杂且测试周期过长,其已经无法跟上经济发展的步伐,不能满足我国快速发展的食品行业对食品检测工作的需求。
因此,建立一种在婴幼儿奶粉中快速、高效、灵敏的检测阪崎肠杆菌的方法至关重要。
本研究是一种基于环介导等温扩增技术而开发的快速检测食品中阪崎肠杆菌的方法。
环介导等温基因扩增技术(Loop Mediated Isothermal Amplification,以下简称“LAMP 法”)是日本荣研株式会社研究发明的核酸等温扩增方法,其利用4个特殊的引物特异识别靶基因的6个特定区域,采用具有强链置换活性的BstDNA 聚合酶,实现在恒温条件下的体外扩增。
附件食品微生物之檢驗方法-阪崎腸桿菌之檢驗1 適用範圍〆本方法適用於一般食品及奶粉中阪崎腸桿菌之檢驗。
2 檢驗方法〆2.1 工作環境〆工作平台須寬敞、潔淨、光線良好,操作平台光度為100呎燭光以上,密閉室內換氣良好,儘可能沒有灰塵及流動空氣。
每15分鐘落菌數不得超過15 CFU/培養皿。
2.2 器具及材料〆2.2.1 乾熱滅菌器。
2.2.2 高壓滅菌釜。
2.2.3 攪拌均質器(Blender)或鐵胃(Stomacher)〆適用於無菌操作者。
2.2.4 天平〆可稱量到2000 g者,靈敏度為0.1 g々可稱量到120 g者,靈敏度為1 mg。
2.2.5 冰箱〆能維持5 ±3℃者。
2.2.6 吸管或吸管尖〆已滅菌,1 mL吸管應有0.01 mL之刻度々5 mL及10 mL吸管應有0.1 mL之刻度。
2.2.7 吸管輔助器(Pipette aid)或微量分注器。
2.2.8 稀釋瓶〆160 mL,玻璃、聚乙烯(polyethylene)、鐵弗龍(Teflon)或其他能耐121℃濕熱滅菌20分鐘以上之塑膠材質,附螺旋蓋。
2.2.9 培養皿〆已滅菌,內徑約9 cm,深度約15 mm,底皿之內外面應平坦,無氣泡、刮傷或其他缺點。
2.2.10 增菌用容器〆附螺旋蓋之125 mL、250 mL、2 L三角錐瓶或廣口瓶々玻璃、聚乙烯、鐵弗龍或其他能耐121℃濕熱滅菌20分鐘以上之塑膠材質。
2.2.11 pH測定儀。
2.2.12 培養箱〆能維持內部溫度在±1℃以內者。
2.2.13 溫度計〆量測溫度範圍1~55℃,最小刻度0.1℃。
2.2.14 水浴〆加蓋,具水流循環系統,能維持水溫溫差在±0.2℃以內者。
2.2.15 接種針及接種環(直徑約3 mm)〆鎳鉻合金、鉑銥或鉻線材質,或可拋棄式者。
2.2.16 曲玻棒〆可滅菌者,直徑3~4 mm,塗抹區域45~55 mm。
2.2.17 試管〆10 ×100 mm,13 ×100 mm,13 ×120 mm,15 ×150 mm,16 ×150 mm試管,或其他適用者。
2.2.18 旋渦混合器(Vortex mixer)。
2.2.19 顯微鏡〆能放大至1000倍以上之一般光學顯微鏡。
2.2.20 載玻片及蓋玻片〆適用於染色及鏡檢用。
2.2.21 研缽、杵。
2.2.22 藥勺、剪刀、小刀、鑷子〆可滅菌。
2.2.23 濾紙及褐色試藥瓶。
2.2.24 無菌濾膜〆孔徑0.45 μm或以下之親水性醋酸纖維膜。
2.2.25 杜蘭發酵管(Durham fermentation tube)〆外徑9 ×22 mm或其他適用者。
2.2.26 試藥〆氯化鈉、硫酸月桂酸鈉(sodium lauryl sulfate)、膽鹽No. 3(bile salts No. 3)、中性紅(neutral red)、結晶紫(crystal violet)、檸檬酸鐵銨(ferric ammonium citrate)、去氧膽酸鈉(sodium desoxycholate)、硫代硫酸鈉(sodium thiosulfate)、草酸銨(ammonium oxalate)、碘化鉀、碘、沙黃O(safranin O)、對-二甲胺基苯甲醛(p-dimethyl aminobenzaldehyde)、四甲基對位苯二胺鹽酸鹽(N,N,N',N'-tetramethyl -ρ-phenylenediamine〄2HCl)、磷酸二氫鈉(NaH2PO4〄H2O)、硝基苯哌喃半乳糖苷(o-nitrophenyl-β-D-galactopyranoside, ONPG)、5-溴-4-氯-3-吲哚-α-D-哌喃葡萄糖苷(5-bromo-4-chloro-3-indolyl-α-D-glucopyranoside)、亮綠(brilliant green)、酚紅(phenol red)、溴甲酚紫(bromcresol purple)、溴麝香草藍(bromthymol blue)、肌酸(creatine)、甲基紅(methyl red)、α-萘酚(α-naphthol)、氫氧化鉀、95%乙醇、無水乙醇、戊醇(amyl alcohol)或異戊醇(isoamyl alcohol)、乳糖、蔗糖、半乳糖醇(dulcitol)、核糖醇(adonitol)、棉子糖(raffinose)、山梨醇(sorbitol)、阿拉伯糖醇(D-arabitol)、氰化鉀、氫氧化鈉、L-離胺酸(L-lysine)、L-鳥胺酸(L-ornithine)、L-精胺酸(L-arginine)、礦物油或液態石蠟油(paraffin oil)及鹽酸等均採用化學試藥級。
2.2.27 試劑〆2.2.27.1 無菌蒸餾水〆蒸餾水900 mL、90 mL、9 mL,分裝於增菌容器或試管中,以121℃滅菌15分鐘。
2.2.27.2 0.85%生理食鹽水〆取氯化鈉8.5 g溶於1000 mL蒸餾水中,分裝於試管內,以121℃滅菌15分鐘。
2.2.27.3 柯瓦克氏試劑(Kovacs’ reagent)〆取對-二甲胺基苯甲醛5 g溶於戊醇或異戊醇75 mL中,再徐徐加入鹽酸25 mL,混合均勻後應呈黃色並須保存於4℃冰箱中。
2.2.27.4 甲基紅指示劑(Methyl red indicator)〆取甲基紅0.1 g溶於95%乙醇300 mL後,再加蒸餾水使成500 mL。
2.2.27.5 歐普氏試劑(Voges-Proskauer test reagents, VP reagents)〆溶液A〆取α-萘酚5 g溶於無水乙醇100 mL中。
溶液B〆取氫氧化鉀40 g溶於蒸餾水中,並使成100 mL。
2.2.27.6 0.5%氰化鉀溶液(0.5% potassium cyanide solution)〆取氰化鉀0.5 g溶於無菌蒸餾水100 mL中(氰化鉀為劇毒物質,本操作務必在抽氣櫃內進行)。
2.2.27.7 礦物油或液態石蠟油〆取礦物油或液態石蠟油20~50 mL,裝入有蓋容器中約1/2滿,以121℃滅菌30分鐘。
2.2.27.8 革蘭氏染色液(Gram stain solution)〆2.2.27.8.1 哈克氏(Hucker’s)結晶紫液(初染劑)〆溶液A〆取結晶紫2 g溶於95%乙醇20 mL中。
溶液B〆取草酸銨0.8 g溶於蒸餾水80 mL中。
將溶液A與溶液B混合,靜置24小時後以濾紙過濾,取濾液作為初染劑。
2.2.27.8.2 革蘭氏碘液(媒染劑)〆取碘化鉀2 g及碘1 g置於研砵中,經研磨5~10秒鐘後,加蒸餾水1 mL研磨,次加蒸餾水5 mL研磨,再加蒸餾水10 mL,研磨至碘化鉀和碘完全溶於水中,將此溶液注入褐色瓶中,再以適量蒸餾水洗滌研砵及杵後,併入洗液,加蒸餾水使成300 mL。
2.2.27.8.3 哈克氏複染液(複染劑)〆取沙黃O 2.5 g溶於95%乙醇100 mL中,供作複染原液。
使用時,取原液10 mL加蒸餾水90 mL,作為複染液。
註〆革蘭氏染色液因放久可能失效,因此若購買成品時,要注意其保存期限,若自行配製者應檢查其染色效果。
2.2.27.9 氧化酶試劑(Oxidase reagent)〆取四甲基對位苯二胺鹽酸鹽1 g溶於蒸餾水100 mL後,貯存於褐色瓶,並置入冰箱中,使用期限以不超過1星期為宜。
2.2.27.10 1 M磷酸二氫鈉溶液〆取磷酸二氫鈉6.9 g溶於蒸餾水45 mL中,徐徐注入30%氫氧化鈉溶液約3 mL,調整pH值為7.0,續加入蒸餾水使成50 mL,貯存於4℃冰箱中備用。
2.2.27.11 硝基苯哌喃半乳糖試劑(ONPG reagent)〆取硝基苯哌喃半乳糖80 mg溶於37℃蒸餾水15 mL中,再加入1 M磷酸二氫鈉溶液5 mL,即為0.0133 M硝基苯哌喃半乳糖試劑,貯存於4℃冰箱中,使用時須加溫至37℃。
2.2.28 培養基〆2.2.28.1 蛋白腖緩衝液(Buffered peptone water, BPW)蛋白腖(peptone)10 g氯化鈉(NaCl) 5 g磷酸氫二鈉(Na2HPO4)3.5 g磷酸二氫鉀(KH2PO4)1.5 g蒸餾水1000 mL攪拌加熱溶解後,以121℃滅菌15分鐘,最終pH值為7.2 ±0.2。
2.2.28.2 加鹽硫酸月桂酸胰化蛋白培養液(Lauryl tryptose broth with 2% NaCl, 2% NaCl-LST)胰化蛋白(tryptose)20 g乳糖(lactose) 5 g磷酸二氫鉀(KH2PO4)2.75 g磷酸氫二鉀(K2HPO4)2.75 g氯化鈉(NaCl)20 g硫酸月桂酸鈉(sodium lauryl sulfate)0.1 g蒸餾水1000 mL加熱溶解後,分取10 mL注入裝有杜蘭發酵管之試管內,以121℃滅菌15分鐘,最終pH值為6.8 ±0.2。
2.2.28.3 紫紅膽鹽葡萄糖培養基(Violet red bile glucose agar, VRBG)酵母抽出液(yeast extract) 3 g蛋白腖(peptone)7 g氯化鈉(NaCl) 5 g膽鹽No. 3(bile salts No. 3) 1.5 g乳糖(lactose)10 g中性紅(neutral red)0.03 g結晶紫(crystal violet)0.002 g洋菜(agar)15 g葡萄糖(glucose) 10 g蒸餾水1000 mL加熱至沸騰溶解,注意不可加熱過度。
於45~50℃水浴中冷卻,最終pH值為7.4 ±0.2。
每培養皿注入約20 mL,凝固後確定表面乾燥後使用。
配製後之培養基應放置於2~8℃冰箱中保存,但須於一個月內使用完畢。
2.2.28.4 阪崎腸桿菌培養基(Enterobacter sakazakii agar, ESA)胰化蛋白腖(tryptone)15 g大豆蛋白腖(soya peptone) 5.0 g氯化鈉(NaCl) 5.0 g檸檬酸鐵銨(ferric ammonium citrate) 1.0 g去氧膽酸鈉(sodium desoxycholate) 1.0 g硫代硫酸鈉(Na2S2O3〃5H2O) 1.0 g5-溴-4-氯-3-吲哚-α-D-哌喃葡萄糖苷(5-bromo-4-chloro-3-indolyl-α-D-glucopyranoside)0.1 g洋菜(agar)15 g蒸餾水1000 mL攪拌加熱溶解後,以121℃,滅菌15分鐘,最終pH值為7.3 ±0.2。